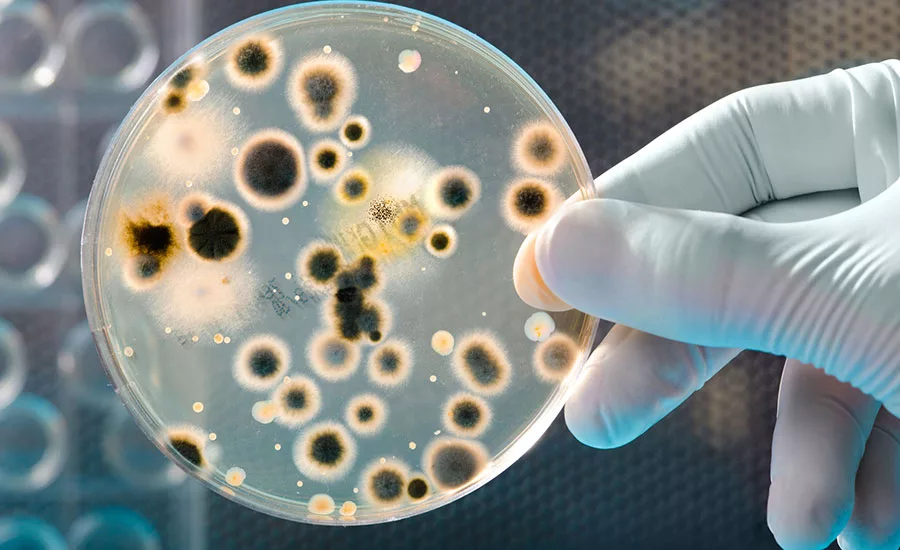
Bacteria culture

Air Quality Testing During Mold Remediation
All that "litters" is not "mold".
Photo: AlexRaths / iStock via Getty Images Plus
Shakespeare should have been a mold remediator. He had a knack for getting to the crux of a matter.
Oftentimes as professional remediators we are accustomed to doing the same thing, the same way. That can be a good thing if the practices we’re following are effective and logical. But following a given protocol merely because “that’s what we’ve always done it” doesn’t typically lead to success.
To “test” or not to “test,” that is the question.
One of the first steps often recommended when visible mold is encountered is to perform some type of mold sampling. Digging a bit deeper than the recommendations from “Joe’s Mold Shack” on the first page of Google, we can learn from the true experts in the field.
For example, according to the U.S. Environmental Protection Agency’s (2010) pamphlet A Brief Guide to Mold, Moisture, and Your Home: "In most cases, if visible mold growth is present, sampling is unnecessary. Since no EPA or other federal limits have been set for mold or mold spores, sampling cannot be used to check a building’s compliance with federal mold standards. (p. 13)"
Additionally, the American Industrial Hygiene Association’s (2019) webpage “Facts About Mold” asserts, “If visible mold is present, then it should be remediated, regardless of what species are present or whether or not samples have been collected.”
So, the moral of the story is, don’t sweat the pre-testing. If you see mold, you have mold…remediate it!
A rose by any other name…
"But I need to tell my customers what species of mold they have!”
Looking for quick answers on restoration, remediation and cleaning topics?
Try Ask R&R, our new smart AI search tool.
Ask R&R →
First question: Why? How is that going to impact your remediation methodology?
Second question and more importantly: Is your testing protocol even accurate?
The traditional standard for air sampling for many years has been the use of Air-O-Cell cassettes, whether collected by a third party or otherwise. These samples are then sent off to a lab which, in turn, sends a seemingly authoritative report identifying different species of mold that are supposedly present in the environment. But how accurate are these reporting methods?
Notice this useful information taken from one widely used laboratory in their document Microbiology Sampling Guide (in respects to the Air-O-Cell cassettes, under disadvantages, the first bullet point): “Fungi cannot be identified to species with this method” (pg. 4).
Mold sampling using this methodology is, at best, inadequate and worse, often misleading.
What “particle” through yonder window breaks – the better approach
So, what’s the answer? Do we entirely abandon the idea of air quality testing, especially post-remediation? Absolutely not!
Image courtesy of Goldmorr
With the increase in “whole house” treatment as part of a remediation protocol, showing the quality of our work is a must. Obviously, a visual inspection will go a long way to ensure that the visible colonies have been addressed. But what about the air quality? Those airborne spores do not recognize room boundaries: they float in the air and circulate throughout the entire building.
The answer is particle count reading. This method does not identify mold species, but as we have already considered, neither do other popular methods. Nor is this information vital to our remediation.
However, airborne particulates and their effect on air quality can be referenced to international standards set by the ISO (International Standards Organization) and WHO (World Health Organization), among others. With the proper training and tools, today’s mold remediation expert can supply a substantive and meaningful report on the condition of a building’s air quality. Visit us at www.goldmorrusa.com to learn more about incorporating these new technologies into your mold remediation efforts.
Image courtesy of Goldmorr
Some are born great, some achieve greatness, and some have greatness thrust upon them.
- William Shakespeare
Be among those taking the lead in tomorrow’s mold remediation, today!
Sources
U.S. Environmental Protection Agency. (2010). A Brief Guide to Mold, Moisture, and Your Home [Pamphlet]. Retrieved from www.epa.gov/sites/production/files/2016-10/documents/moldguide12.pdf
American Industrial Hygiene Association. (2019). Facts About Mold. Retrieved from www.aiha.org/publications-and-resources/TopicsofInterest/Hazards/Pages/Facts-About-Mold.aspx
EMSL Analytical, Inc. (2014). AIR-O-CELL. In Microbiology Sampling Guide (Air Sampling for Total Spore Counts). Retrieved from https://www.emsl.com/PDFDocuments/SamplingGuide/EMSLMicrobiologySamplingGuide.pdf
Looking for a reprint of this article?
From high-res PDFs to custom plaques, order your copy today!






